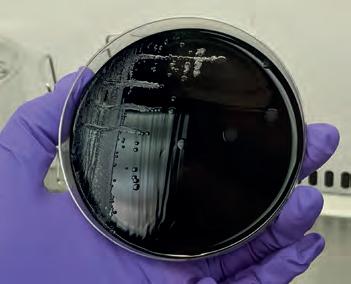

Moredun ISSUE 25 | SPRING/SUMMER 2023 magazine Zoonotic Disease and One Health Flock to the Show Worm egg count app www.moredun.org.uk
In this Issue:
p1-2 News
p3 Moredun Scientific and Pentlands Science Park update

p4 Spatial transcriptomics: investigating infectious disease in a whole-tissue context
p6 PhD research - zoonotic disease and one health
p8 Moredun to recruit beef cattle farmers for new research project
p9 Stop the spread in the Western Isles
p10 Out and About
p12 Meet Moredun’s newest recruits
p13 FEC Check: understanding sheep roundworm egg count
At the time of writing, spring has finally arrived in Scotland and we look forward to attending this year’s agricultural events, including the Royal Highland Show. This year we have a special addition to our RHS line-up in the form of a beautifully painted sheep for the ‘Flock to the Show’ initiative – see p10 for the inspiring artwork by PhD student Eilidh Geddes.
Horse enthusiasts from around the UK gathered at Moredun and online at the end of March to listen to the latest updates on Equine Grass Sickness research. This day of presentations, panels and discussions celebrated our achievements so far and looked towards progress in solving the EGS puzzle –see p2 for the full report.
We are well known for our work into zoonotic diseases and use a ‘One Health’ approach to studies to ensure both animals and humans are kept safe. We’re delighted to be training the next generation of scientists to tackle this important issue, so turn to p6-7 to learn about what PhD student Karen Keegan has been getting up to on the Orkney Isles.
On the topic of training the next generation, our Education Team has had a successful first season of taking the Moredun BioBus to local primary schools to inspire them into a future scientific career through some fun and educational activities. Bacteriology, parasitology, and pathology have all been covered, and we have engaged with over 300 pupils across 6 schools - see p11 for details. We look forward to continuing when schools return after the summer break!
Have a wonderful spring/summer and do come and say hello if you see us out and about.
Julie Fitzpatrick Scientific Director and Chief Executive

The Moredun Foundation is a company limited by guarantee, registered in Scotland No. SC151865.

The Moredun Foundation is a charity registered in Scotland, No: SC022515

Address: Pentlands Science Park, Bush Loan, Penicuik, Midlothian EH26 0PZ
Cover image: Dr Marc Faber, Moredun
Moredun Magazine | Spring/Summer 2023
Magazine
Moredun
Director’s comment
Contents Moredun magazine is produced twice a year and is available free of charge. Designed and Produced by Moredun Communications Centre ©2023. All images, unless otherwise stated, are ©Moredun. To subscribe, contact: Moredun Communications Team,
Science Park,
Loan, Penicuik, Midlothian EH26 0PZ Comments, ideas, suggestions? Get in touch and let us know.
tel:
5111 fax:
6111
Pentlands
Bush
Please contact: Moredun Communications Team, Pentlands Science Park, Bush Loan, Penicuik, Midlothian EH26 0PZ
+44 (0)131 445
+44 (0)131 445
email: info@moredun.org.uk web: www.moredun.org.uk @MoredunComms
The Princess Royal visits Moredun to hear how story telling can help to communicate science
On Friday 4th November 2022, Her Royal Highness The Princess Royal attended a special event held at Moredun to hear about how storytelling techniques can be used to communicate science more effectively to inspire change and uptake of new technologies.
The Princess Royal was joined by over 80 guests to hear more about Moredun’s work
in using creative ways to communicate new advances in science and technology to encourage more people to change practices to improve the health and welfare of livestock and sustainable agricultural practices.
The speakers at the event included John Cameron, Honorary President of The Moredun Foundation who emphasised the importance of effective communication between scientists and farmers to make sure that the science could maximise benefits
Other speakers included:
• Stewart Burgess - Prevention and control of sheep scab
• Chris Cousens - Ovine pulmonary adenocarcinoma (OPA) and thoracic scanning
• David Smith and Lynsey MelvilleChallenges and inspiration for a career in scientific research
• Lee Innes - Livestock Keepers project in collaboration with Scottish photographer Kevin McCollum.
During the visit, The Princess Royal met guests including a group of post-graduate students and early career scientists along with those representing the farming industry, public engagement in science and the Equine Grass Sickness Fund. Her Royal Highness also participated in a private tour of Moredun’s laboratories to speak first hand to the scientists about the latest research advances.


Before leaving, The Princess Royal planted a tree at Pentlands Science Park as part of the Queen’s Green Canopy and in memoriam of Her Majesty Queen Elizabeth II.

Moredun Magazine | Spring/Summer 2023 1 NEWS
Planting an oak tree as part of the Queen’s Green Canopy.
Discussing Louping Ill with Dr Beth Wells and Dr Mara Roccition.
Dr David Griffiths and Dr Jo Moore discuss discuss the new Louping Ill virus vaccine research.
Working together to tackle equine grass sickness
(R(D)SVS), David Miskelly (Woodside Vets) and James Risk (Forth Valley Vets).
The fundraising panel was chaired by David McLelland of Norvite, asking ‘How do we meet the fundraising challenge?’ Our distinguished panelists were Melody Ashcroft (Heald Town Highland Pony Stud), Jane Hutcheon (Norbrook), Helene Mauchlen (BHS Scotland), Yvonne Maclean (Ross-shire Fundraising Group) and Sylvia Ormiston (Balmoral Highland Pony Stud).
A highlight of the day was the EGSF Fundraising Awards and we were honoured to have so many of our supporters present. The Awards were presented by Sally McCarthy, Chair of the British Horse Society, whose generous funding has supported the first three years of the EGS Biobank. The Trowan Trophy for Most Fun Loving Supporter went to Carrie Bain of Harelaw Equestrian, Longniddry. The Heidi Award for Outstanding Support went to Melody Ashcroft of Heald Town Highland Ponies.
Almost 100 delegates and speakers gathered at Moredun on 29th March for an action packed day considering the topic ‘Working Together to Tackle Grass Sickness’, with another 30 people joining online.

This day of presentations, panels and discussions brought together researchers, vets and fundraisers, to celebrate our achievements so far and to make progress in solving the Equine Grass Sickness (EGS) puzzle.

Our speakers gathered from across the UK, representing every branch of grass sickness research, and the major equine charities.
Roly Owers, CEO of World Horse Welfare and Prof Chris Proudman of the University of Surrey’s School of Veterinary Medicine opened the day with keynote speeches on the importance of working together and the power of partnerships.
The first topic of the morning explored ‘Gathering the Evidence’, with Dr Beth Wells of MRI, Prof Elspeth Milne, Prof Bruce McGorum and Prof Ian Poxton from the University of Edinburgh, Dr Leonie Hunter
(EGSF Committee) and Dr Richard Newton of the University of Cambridge presenting on the EGS Fellowship project and setting up the EGS Biobank as a national resource for research, the recent lipofuscin project, mycotoxins, clostridial vaccination and the importance of equine surveillance in tacking disease.
Moving on to new technologies, Moredun’s Dr David Smith spoke about the pioneering work to establish equine 3D gut organoid in vitro cultures and the implications for EGS research. Dr Joy Leng of the University of Liverpool covered the Omics sciences and how these could be used in EGS research, and Dr Hayley Coulson of the University of Edinburgh spoke about her study on environmental risk factors and how this may be used to predict risk of Equine Grass Sickness Fund (EGSF) based on weather patterns.
A change of pace in the afternoon saw two interactive discussions. The vet panel, chaired by EGSF Chair Anne Logan, discussed where practice meets science, and how vets can support the EGS Biobank. Thanks to our panel of experienced vets who have all supported the biobank: Mary-Jo Grant (Conanvets), Graham Hunter (IVC), John Keen
Winners of our Silver Salver awards were Sarah Houlden of Strathearn Eventing Hunter Trials, The Crathes Charity Show, Martin Johnston Ireland’s Bonus Ball and LifeScan Scotland’s matched funding for the Ross-shire Fundraising Group, Team Chiblet of Harelaw Equestrian Onesie Rides, Central Scotland Shetland Pony Group’s Kelpies Ride and A Trial of Cocktails and Contributions at Belwade Farm.
We are very grateful to our sponsors Norbrook, Norvite and TopSpec for supporting the day, to Pentlands Science Park for the superb facilities, and to The Moredun Foundation for hosting the day.
Moredun Magazine | Spring/Summer 2023 2 News
The conference attracted people from across the horse industry as well as researchers and veterinary practitioners.
The Harelaw Equestrian group winners.
Contract Biosafety Testing at Moredun Scientific

Moredun Scientific runs a well established business unit with an annual turnover of £2M which is focussed on contract biosafety testing for the biopharmaceutical industry. This involves testing a range of biological materials including cells lines used in the manufacturing of biological medicinal products. The team tests a range of biopharmaceutical types including vaccines, therapeutic antibodies, recombinant proteins and cell therapy products.
The testing is essential to ensure that the biopharmaceuticals are free from any contaminating materials and infectious agents (e.g. bacteria, viruses, mycoplasmas) that may be carried over from the cells used to produce them or from the manufacturing process. The tests are carried out under tightly controlled conditions regulated in the UK by the Medicines and Healthcare Regulatory Authority (MHRA).
During the recent pandemic the team were involved in testing many batches of COVID vaccines. The most recent development has been the establishment of mycoplasma testing which requires specialist skills and
is conducted in our Good Manufacturing Practices (GMP) compliant facility at Moredun.
The need for Biosafety testing services is increasing in line with the growing number of biopharmaceuticals under developmentmany manufacturers outsource this specialised testing to companies such as ourselves. There is also an ongoing demand for vaccine products. We work with clients across the globe including companies based in the Far East.
To learn more please contact us:
info@moredun-scientific.com or visit our website: www.moredun-scientific.com
We are delighted to welcome some new tenants to Pentlands Science Park

Green Bioactives is an innovative biotech start-up from the University of Edinburgh that has developed a unique, sustainable and economical plant cell-based biomanufacturing platform. The platform has been used to develop a portfolio of natural products that are vital to many industries but are difficult to produce sustainably or economically using traditional methods. The team can identify, isolate and cultivate plant vascular stem cells, which can differentiate into distinct plant tissues to produce a range of target molecules currently used in cosmetics, nutraceuticals, agriculture and pharmaceuticals. An example of one such class of molecules is saponins from soap bark, which are of great interest to the cosmetics and pharmaceutical industries. The soap bark tree is native to Chile and the saponins it produces can be used as a vaccine adjuvant and an emulsifier in cosmetics. Green Bioactives currently provides natural products for several world-leading partners in its target
industries, and has its own pipeline of in-house products in development, with the first to be launched later this year.
Resolution Therapeutics is a preclinical biotechnology company developing macrophage cell therapy to treat inflammatory organ disease. Their initial focus is chronic liver disease - the only chronic disease still on the rise in western countries, affecting millions of people worldwide. For patients with end-stage liver disease (cirrhosis) the only therapeutic option is liver transplantation, a complex surgical procedure
limited by complications and a shortage of donors. The company’s lead product is an autologous engineered macrophage therapy designed to treat cirrhotic patients. The company was founded in 2020 based on over a decade’s research in macrophage and liver disease by Prof. Stuart Forbes and Prof. John Campbell. Today, the company is a leader in developing and manufacturing macrophage cell therapy with potential applications in a wide range of life-threatening conditions. The company, backed by Syncona, has raised over $50M to advance the lead product into clinical trials.
Moredun Magazine | Spring/Summer 2023 3 Moredun Scientific/Pentlands Science Park
Spatial transcriptomics: investigating infectious disease in a whole-tissue context
The tools to investigate infectious disease in farmed animals have made major advances over the past two decades, with molecular sequencing becoming more accessible and affordable. DNA sequencing allows us to investigate changes in the host animal genome that influence an animal’s response to disease, e.g. increased resistance versus increased susceptibility to infection.
Within individual cells in the body DNA is transcribed to RNA which is then translated to proteins which enable the cell to respond to a
challenge, e.g. infection by a virus. The amount of RNA and protein produced varies depending on many factors including the health status of the animal and the type of infectious agent. By sequencing the RNA that is present in a tissue sample we can study the cell response at a given point in time over the course of infection and recovery.
For most types of RNA sequencing the RNA is either extracted from an intact piece of tissue from the host or pathogen, or the tissue sample is treated to enable separation of different cell types from which the RNA is extracted. Both these approaches result in the loss of information related to the tissue architecture, i.e. the relative location
of individual cells within the tissue. Such information is important as the response to a pathogen may be highly localised to areas adjacent to the pathogen, or within specific locations within tissues.

A recent technological development has been able to overcome this problem: “spatial transcriptomics” enables us to retain the link between the RNA produced by a cell and the position of the cell in a tissue sample. In the spatial transcriptomics platform RNA is collected using barcoded “probes” that are applied to the tissue sample and then collected using UV-light technology.
Moredun Research Institute is currently leading a research consortium spanning the UK and Ireland including research partners at the Roslin Institute, The Pirbright Institute, the University College Dublin, the University of Glasgow, Teagasc and Aberystwyth University. This consortium beat 180 global applicants to be awarded an industrial grant by NanoString Technologies to develop the world first custom probe set for cattle and sheep. With this panel of RNA probes we are able to investigate key genes involved in many types of cellular responses including the growth, differentiation, degeneration and death of immune and non-immune cells. The consortium will apply these probes to investigate key diseases in their research portfolios including parasitic roundworms in cattle and sheep, ovine enzootic abortion, ovine pulmonary adenocarcinoma (OPA),
Moredun Magazine | Spring/Summer 2023 4 Research
An MRI-led consortium was awarded a development grant by NanoString Technologies to apply spatial transcriptomics to study infectious disease in cattle and sheep.
“The power of this technology lies in its ability to investigate the cellular response to disease while simultaneously capturing the spatial context of the cellular response within the tissue.”
sheep scab mite, bovine respiratory syncytial virus and foot and mouth disease virus.
The technology itself is fascinating. Spatial transcriptomics exploits the tissue architecture, which is preserved by fixing tissues in formalin, embedding them in paraffin wax, and cutting them into very thin slices or “sections”. These tissue sections are 5 micrometer thick, or approximately 1/20th the thickness of a human hair. Tissue samples that are embedded in wax can be stored for many years with minimal loss of sample quality. This enables us to utilise both recently collected and archived samples which can be as old as 15+ years.
Prior to analysis, the tissue sections are chemically treated to expose the RNA fragments present within fixed tissue and

encourage the RNA fragments to bind to the reporter probes. Individual probes are released by exposing them to UV-light which is targeted to a particular region of interest using a mirror array consisting of 1 million onemicron sized mirrors. A region of interest can be further refined by incorporating biomarkers that highlight a particular part of the cell, e.g. the nucleus, or indicate the location of an infectious agent.
Ovine pulmonary adenocarcinoma is an infectious lung tumour of sheep for which there is no live-animal test, no treatment, and no cure. To investigate how lung tumours develop in the host animal we used tissue samples collected from naturally infected sheep. In the Figure (below) we used biomarkers for the causative agent (Jaagsiekte
sheep retrovirus) (yellow-green) and cell nuclei (blue) to allow separation of lung tumour tissue (red) from non-tumour tissue (magenta). This allows us to identify key genes which are expressed at a higher or lower level in the lung tumour versus the adjacent tissue. These key genes represent potential targets against which we can develop novel diagnostic tests, treatments or preventative vaccinations.

In the case of the brown stomach worm, Ostertagia ostertagi, we are interested in how these parasitic roundworms modulate their microenvironment during the infection. These roundworms invade into the gastric mucosa of the abomasum and sit in the gastric glands where they develop into mature adults. To investigate what is happening within a gland infected with a worm we can isolate the cell layer the worm is in immediate contact with and compare these to neighbouring and distal glands over the course of infection.
The power of this technology lies in its ability to investigate the cellular response to disease while simultaneously capturing the spatial context of the cellular response within the tissue. The fact that spatial transcriptomics is applied to fixed tissues allows us to perform retrospective analysis of archived material of difficult (and often expensive) disease trials.
As a result of the collaboration between the Moredun-lead consortium and NanoString Technologies spatial transcriptomics has made its debut in the veterinary field. Samples prepared and analysed by the Moredun Research Institute team represent a worldfirst in the application of this cutting-edge technology in cattle and sheep.

Moredun Magazine | Spring/Summer 2023 5 RESEARCH
Moredun and Pirbright representatives for the first analysis at the Nanostring laboratory in Amsterdam.
From left to right: Dr Marc Faber, Dr Ambre Chapuis, Dr Katie Hildersley, Dr Wilhelm Gerner and BSc Joanna Wells.
Bovine abomasum glands infected with the brown stomach worm Ostertagia ostertagi (left). Separating the tumour micro-environment of OPA in a sheep lung (right).
PhD Research by Karen Keegan: Zoonotic Disease and One Health
Disease-causing bacteria that are transmitted from animals to humans, known as zoonotic bacterial pathogens, can have far-reaching effects on human and animal health. Using a ‘One-Health’ approach, Moredun PhD student Karen Keegan seeks to advance detection and identification of these microbial risks, with a focus on zoonotic pathogens and antimicrobial resistance (AMR) that can be spread between wildlife and livestock species.
My PhD is specifically focussed on foodborne zoonotic pathogens such as Campylobacter, Salmonella and antibiotic resistant E.coli, which are bacterial pathogens that do not always cause overt disease in animals but can be transmitted through the human food chain via contaminated animal products. Once in the human gut, these pathogens can cause gastroenteritis and diarrheal disease, which can be severe enough to warrant antibiotic use and even hospitalisation. Of additional concern is the ability of some bacteria to exchange genetic information between themselves and other bacterial species, including genes that confer antibiotic resistance. As
bacteria naturally move between different environments and hosts, this could lead to the development of antibiotic-resistant diseases in susceptible individuals.

One region that has been experiencing close associations between wildlife and livestock is the Orkney Isles, where numbers of greylag geese (Anser anser) have increased rapidly over the last 20 years. An estimated 20,000 resident geese are present all year round, with an additional 40,000 migratory geese arriving from Iceland in the winter months, taking advantage of the milder climate and greater food availability. The geese feast on the ready supply of grass and crops,

leading to high levels of faecal contamination on cattle pastures. Geese and cattle are natural carriers of certain zoonotic pathogens, such as Campylobacter, that can survive in their guts and be shed through their faeces. The transfer of these bacteria between animal species via faecal contamination and the subsequent risks for transmission to humans through food and environmental routes is poorly understood. The migratory geese populations on Orkney are also particularly relevant for studying antimicrobial resistance (AMR) transmission, as migratory geese have been found to carry AMR genes over large distances and are touted as vectors for widespread AMR dissemination. I have been fortunate to develop a fruitful collaboration with Dr Pedro Rodrigues at the Rif Field Station in Iceland to explore this topic further; we have successfully collected faecal samples from a population of Icelandic greylag geese through funding from the International Network for Terrestrial Research and Monitoring in the Arctic (INTERACT), with more sample collection scheduled this year
One of the reasons that waterfowl species such as greylag geese are considered highrisk spreaders of zoonoses and AMR is due in part to their close association with aquatic environments. These environments are
Moredun Magazine | Spring/Summer 2023 6 Research
Cultured Campylobacter spp. isolated from a goose faecal sample.
The numbers of greylag geese have increased rapidly over the last 20 years on the Orkney Isles.
considered important routes for zoonoses and AMR transmission, largely due to land-to-sea contamination from sources such as sewage, hospital and farm effluent. This relates to another aspect of my PhD, which seeks to understand accumulation of zoonotic bacteria and AMR in the gut microbiome of grey seals (Halichoerus grypus). Seals inhabit coastal areas that can readily accumulate these microbial pollutants and as such are regarded as excellent indicators of ecosystem health.
By sampling livestock and wildlife faeces, as well as environmental samples such as water, I hope to get a better understanding of what foodborne pathogens and AMR exist in the wider environment and to what extent they are transmitted between species. A very exciting aspect of my PhD is the use and evaluation of an advanced genomic sequencing technology, Nanopore sequencing, to try and answer these questions. This innovative technology, developed by Oxford Nanopore

Technologies (ONT), enables researchers to sequence much longer fragments of DNA from a sample, allowing more accurate identification of what species and genes are present. As it is a relatively new technology, I am comparing the DNA sequencing results I obtain from an ONT MinION sequencer with more traditional methods of detecting bacteria and antibiotic resistance, such as culturing, or ‘growing’ bacteria on nutrient rich agar plates. The findings from this work will also inform the use of this technology in detection of animal pathogens and other zoonotic microbial species.

My PhD is funded by the East of Scotland Bioscience Doctoral Training Partnership (EASTBIO DTP), of which Moredun is a partner institute. EASTBIO seeks to deliver interdisciplinary training to bioscience PhD students in preparation for careers in academia and industry, offering a diverse range of training programmes throughout
the PhD. First year students are also tasked with delivering a one-day conference style ‘thematic meeting’. I found this a very thought-provoking experience, as the meeting I helped host, centered on the theme of rewilding, with invited speakers covering topics such as on-farm rewilding techniques and the reintroduction of native oysters. EASTBIO also encourages students to think early on about their career goals post-PhD, and this is evident through the ‘Professional Internship for PhD students’, a 12-week internship spent in any non-academic field of choice. This provides a perfect opportunity to explore career options and try something new – while also allowing us a little break from our often-hectic PhD research! I feel incredibly fortunate to be working on such an exciting topic in a very supportive research environment here at Moredun and I am looking forward to what I may uncover over the next few years.

Moredun Magazine | Spring/Summer 2023 7 RESEARCH
“One of the reasons that waterfowl species such as greylag geese are considered high-risk spreaders of zoonoses and AMR is due in part to their close association with aquatic environments.”
Collecting goose faecal samples from farmland in Orkney.
A MinION sequencer, one of the sequencing devices available from Oxford Nanopore Technologies (nanoporetech.com).
Greylag geese are considered high-risk spreaders of zoonoses and antimicrobial resistance.
Moredun aims to recruit beef cattle farmers for new research project
Scientists from Moredun Research Institute and Scotland’s Rural College (SRUC) are seeking to recruit farmers for a new Scottish Governmentfunded project, Monitoring efficiency.
Vaccines, antibiotics and other medicines are essential to limit the impacts of parasites and pathogens on livestock health and productivity, but it is critical that treatments are applied appropriately in order to ensure they have maximum efficacy. Inappropriate treatment timing, dosage or product choice represent unnecessary financial costs and may also contribute to the evolution of drug resistance in parasites and pathogens.
In addition, the extent to which diseases impact animal performance is not well-known outside of controlled experimental studies. Indeed, we have surprisingly few estimates of the impact of disease on performance under farm conditions where, unlike in experiments, animals are challenged by multiple diseases and seasonal variation in nutritional and reproductive state.
Veterinary medicine records are routinely collected by farmers and provide information on both the medicines that are used on a given farm and on the diseases that animals are exposed to.

Addressing medicine usage and quantifying
the impact of disease on performance is a demanding task, requiring links to be made between on-farm records of veterinary medicines, and measures of performance collected either on farms or at the abattoir when the animal is slaughtered. Farm medicine records represent an excellent proxy for disease exposure as they should contain information on the likely diseases an individual animal has been, or is expected to be, exposed to.
Our research project aims to:
1. Provide a picture of veterinary medicine use in UK beef cattle and identify factors associated with variation in medicine use, such as location, seasonality and farm characteristics;
2. Link medicine records with abattoir data to identify associations between diseases and performance parameters such as age at slaughter and weight gain.
To achieve these aims, we need good-quality data. We are aiming to recruit farmers who are willing to share their medicine record data and are also working with abattoirs to link medicine records to animal performance. This will result in two data sets for our project: a ‘core’ data set consisting of medicine records to fulfil Aim 1, and a subset of data linked to abattoir records to fulfil Aim 2.
The only requirement from farmers interested in contributing data is that they record their medicine use electronically, for example in farm management software. No personal data such as farm location or contact details will be shared and all data, including animal identities, will be anonymised prior to analysis and dissemination of results. There will be no immediate benefit to contributing farmers because we aim to provide a broad overview of medicine use and links to performance, rather than an appraisal of individual farms. Results from the project will, however, be disseminated to participating farmers and the wider community including farmers, vets, researchers, and other industry representatives.
Dr Adam Hayward of Moredun Research Institute, who is leading the project, said “Obtaining information on veterinary medicine use will enable us to see what parasites and pathogens are most prevalent, and where and when they are occurring. By linking this to animal performance data we will also gain a better picture of the cost of these diseases to the industry and how we can target interventions.”
Dr Carol-Anne Duthie, head of SRUC’s Beef and Sheep Research Centre, said “we are excited to be working alongside colleagues from Moredun on such an important issue. Through direct engagement with the farming sector, the project will provide a clearer understanding of the key disease challenges affecting Scotland’s beef sector and their economic impact”.
The project runs until 2027. The next two years will be spent recruiting farmers and collecting data, before spending the final two years collating and analysing the data and disseminating findings.
For more information on the project and how to take part, please contact Dr Adam Hayward at Moredun Research Institute (adam.hayward@moredun.ac.uk).
Moredun Magazine | Spring/Summer 2023 8 Research
Stop the Spread in the Western Isles
farmers and industry to demonstrate a more sustainable method of controlling the disease through serological testing.
This Lewis & Harris sheep scab project offered free sheep scab testing during the week beginning 13th February 2023. Vets from the Old Mill Veterinary Practice in Stornoway collected blood samples from 12 sheep per flock, with close to 100 farmers participating in the testing. For those flocks that test positive, the project team will provide free treatment advice and will cover reasonable treatment costs to ensure that animals are treated in a timely and coordinated manner.
Moredun Research Institute are leading a Scottish initiative on the Western Isles to tackle sheep scab, funded by the Scottish Government. Working with the Lewis & Harris Sheep Producers Association, areas requiring further support will be identified using an ELISA blood test to better control sheep scab in the future.


Sheep scab has been identified as one of the most important diseases for UK sheep farmers from both financial and welfare perspectives. It is considered to be the most contagious endemic ectoparasitic disease affecting sheep in the UK, causing annual loses of £78-200M to the UK sheep industry. Economic losses associated with reduced performance are due to loss of ewe condition, poor lamb growth rate, reduced quality of sheepskins and wool damage. Untreated infestations of sheep scab can, in some cases, be fatal.
The ELISA blood test detects antibodies to a protein found only in the sheep scab mite, which means that the test can accurately say whether infestation is due to the scab mite or another ectoparasite, e.g. lice. The test can detect the presence of mites within 2 weeks of infestation and before the onset of clinical signs, which is important to effectively control the parasite.
Moredun have been working with a number of partners across all four nations of
the UK to benchmark the use of the blood test in local, regional and national control programmes. The Institute is working closely with government agencies, funding bodies,
Stewart Burgess, who is leading the project from the Moredun Research Institute said: “We’re delighted that so many sheep-keepers signed up to this initiative because, with a disease like scab, it’s so important that people act in a joined-up way to get on top of the problem. The funding from Scottish Government has allowed us to start this process and we’re now looking forward to the benefits in sheep welfare and productivity which will result from a successful campaign.”
Moredun Magazine | Spring/Summer 2023 9 RESEARCH
Acquiring blood samples on the Western Isles.
Close to 100 farmers participated in the testing scheme.
Out and About
PhD student Eilidh Geddes was chosen to paint a very special sheep as part of the “Flock to the Show” art initiative, organised by the Royal Highland Show



Golden Shears 2023 will see the best shearers and wool handlers from over 30 different countries compete at this year’s Royal Highland Show to become the World Champion. To celebrate, a competition called ‘Flock to the Show’ was launched which saw Scottish artists apply to paint one of 35 sheep sculptures that would then tour the country before being displayed at the show.
One of our PhD students, Eilidh Geddes, overcame stiff competition to be chosen to paint her own sheep, called ‘A Land of Parasites’. The design depicts the contrast between our picturesque landscapes and the hidden parasite challenge that lies within. The purpose of this design was to bring awareness to this issue, bringing together Eilidh’s research on sustainable parasite control, and work as a pet portrait artist. The design depicts three parasites of major importance to the sheep industry: sheep scab, roundworms, and liver fluke, and demonstrates where they are commonly found within the landscape. Growing up in Caithness, Eilidh began drawing at a young age and her hobby quickly grew into a thriving ‘pet portrait’ business. However, having found a passion for agricultural research, Eilidh now resides in the Scottish Borders, pursuing a PhD at Moredun Research Institute investigating sustainable parasite control on Scottish hill and upland sheep farms. While most of Eilidh’s work features dogs and cats, she enjoys creating pieces which demonstrate her passion for Scottish agriculture. Consequently, Eilidh was thrilled to
be selected to paint a sheep for ‘Flock to the Show’ to use her art to highlight issues facing Scottish agriculture.
Meet the whole flock here: https://www.royalhighlandshow.org/ flock-to-the-show/meet-the-flock/ Eilidh
F5: Future, Food, Farming, Fish and Forestry
Moredun recently hosted the F5: Future, Food, Farming, Fish and Forestry conference together with the Royal Society of Arts Rural and Environmental Network and SEFARI. The themes of the conference were to bring together a wide diversity of participants from across different sectors to enable inclusive discussions on sustainable agriculture and land use practices to support many essential goods and services while looking to reduce impact on our natural resources and move towards net zero targets.
The F5 conference encouraged active participation of young delegates from different
sectors to put forward their views and vision for the future. There are huge challenges in deciding the best way forward for agriculture and land use, and also many opportunities through better awareness and understanding of alternative and opposing views and new possibilities through cooperative and multidisciplinary working.
However there is a real gap between the aspiration and the route to delivery of that aspiration and this requires an inclusive process to ensure the many different viewpoints are heard and considered in making intelligent policy in a very complex area.
Moredun Magazine | Spring/Summer 2023 10
... And at the end of her painting marathon!
with her sheep at the start...
Inspiring the Next Generation
in a swab and draws a pattern on the jelly to represent growing a colony of bacteria. The petri dishes are then placed in our special ‘incubator’ (a dark box with a black light) to see if it glows. If it does, then the sheep are deemed to be sick with a bacterial infection and in need of treatment.
Thanks to the generous sponsors of the Moredun BioBus, our educational team are embarking on a new project where the BioBus will be taken to primary schools all around Scotland over the next couple of years.

The workshops we offer have been designed in conjunction with our scientists to ensure all information is up to date, accurate and relevant to real life. Each activity is an excellent addition to the Scottish Curriculum for Excellence, hitting outcomes such as “Body Systems and Cells”, “Biodiversity and Interdependence”, “Health and Wellbeing” and “Social Studies: People, Place and Environment”.

The workshop we have used this year is called “Disease Detectives”, where the children can get hands-on with science. An introduction to parasites, bacteria and viruses is given to the group to start with, with our bag of “fluffy bugs” always turning out to be very popular! The group is then split in half, with half venturing onboard the BioBus to get up close and personal with real parasites and learn how vaccines are made. Meanwhile, the rest of the group remain outside to learn how a vet or scientist might test and diagnose a sick sheep. Using petri dishes filled with strawberry jelly, each pupil takes a vial of ‘sheep snot’ (glow-in-the-dark liquid!), dips
Our first visit was to Crookfur Primary in Newton Mearns, near Glasgow, where our Education team interacted with 72 P5 pupils (though thankfully not all at once!). Some brilliant comments were made during the day, such as “This is the coolest thing ever”, “I wish I could do this every day!”, and “I know I’m only in primary school, but if I want to do this for a job later who do I call?”


The second school we visited was Echline Primary in South Queensferry, Edinburgh, where we got to know 30 P1 pupils.
All of the children were an absolute delight to work with - very engaged, curious and excited, and a credit to their schools.
The feedback we have received from teachers and pupils so far has been very encouraging:
Our workshop was simplified to suit the age of the children, so after meeting the fluffy bugs they played a running game where they had to race to a particular station depending on whether a bacteria, virus or parasite was pulled out of the bag – it certainly kept them warm! Then they all had a chance to board the bus and meet the real parasites.
In March we visited P4-P5 classes at Mauricewood Primary in Penicuik, one of our local schools – and we experienced all weather conditions in just a few hours! St Ronan’s Primary in Innerleithan was next, visiting their P7 classes where we could have stayed all day answering all of their questions. Hawthornden Primary in Bonnyrigg, Midlothian is another local school that we visited in April, where the children were excited to notice that the Moredun scientists they met were all women! Our final school of this season was Niddrie Mill Primary in the south-east of Edinburgh whose P7s got to look at real brain tissue samples under a microscope.

“[The children] loved talking to real scientists about their jobs. They said they were very patient at answering all of their questions and that they explained things really well.”
“Everyone thought the visit was amazing and they thoroughly enjoyed it.”
Single words used by the children to describe the visit: Excited, Amazed, Awesome, Inspired, Nervous, Puzzled, Happy, Brilliant, Curious, Astonishing, Knowledgeable, Fantastic.
Moredun Magazine | Spring/Summer 2023 11 OUT AND ABOUT
Disease Detectives.
Crookfur Primary in Newton Mearns, near Glasgow.
Echline Primary in South Queensferry, Edinburgh.
Hawthornden Primary in Bonnyrigg.
A delightful thank you note from Mauricewood Primary in Penicuik.
Meet Moredun’s newest recruits
What is your job role?
I am a veterinarian and I am here to provide clinical veterinary medical and surgical care for the animals that we have at Moredun and at Firth Mains Farm. My first Postdoc position was also at Moredun, during which I helped develop the diagnostic test for encysted cyathostomins in horses that is commercially available since 2017. After moving to the Roslin Institute and APHA, I saw the job advert and I felt that coming back would be the best step for my career.

If you could meet any living person for dinner, who would you pick and why?
I would meet Joanne Rowling, author of the Harry Potter books. It would be amazing to “pick” her brain as she seems to be an extremely clever person. Moreover, she is local. If anyone reading this knows her, could you please try to arrange this on my behalf?!
What is your job role?
I’m currently implementing a new system to manage members and donations. Once that is done, I will focus on improving our intranet which will hopefully make everybody’s life a little bit easier.
If you could meet any living person for dinner, who would you pick and why?
Shauna Coxsey (a British professional climber), to get some training tips.

What is your job role?
I’m working as Postdoc on a project to develop a vaccine against Poultry Red Mites (PRM). I am very excited about this project because it is based on the previous studies of our group and applies novel RNAi technology to select targets for a new vaccine. Briefly, I am using some dsRNA to interfere with the genes of PRM expression and check the importance of these genes for the survival of the mites. Based on these findings, I will design some immunogens to perform the vaccine trials in chickens and hopefully obtain an effective vaccine to control the PRM infestation.

If you could meet any living person for dinner, who would you pick and why?
I would invite “Pepe Mujica”, ex-president of Uruguay, because I am very curious to understand his strategies to make his country one of the best in life quality and education in Latin America. I have already read a lot of his texts, and I am a fan of his work and his point of view of the world.
Moredun Magazine | Spring/Summer 2023 12 Spotlight
Eliezer Ramos
Postdoctoral Research Scientist
Sara Selzer
Sharepoint and CRM Administrator
Thomas Tzelos
Veterinary Clinical Officer
FEC Check: understanding sheep roundworm egg count results at a glance
Parasitologists at Moredun have developed a farmer-facing, free, online tool which helps with the interpretation of faecal egg count results for roundworms in sheep called ‘FEC Check’. https://app. moredun.org.uk/fec
Roundworms are an ongoing challenge for sheep farmers in Scotland. Whilst acute infection can be fatal, most roundworm infections result in poor growth rates and reduced production efficiency. To meet upcoming environmental targets, roundworm infections must be controlled effectively and sustainably.
Faecal egg counts can be used to target anthelmintic usage: monitor whether animals require treatment, when to administer it and to check whether the treatment was effective. Such targeted approaches can reduce chemical usage, potentially slowing the development of anthelmintic resistance and providing additional environmental and economic benefits.
Although the test itself is simple, translating the results into management decisions can be more difficult, particularly for those who are new to testing. Testing is available through diagnostic labs, veterinary surgeries and is increasingly performed independently onfarm. We know from previous studies that support and advice from test providers is variable, meaning that some farmers receive results without context or interpretation. Although resources on the practical meaning of results are available (www.scops.org. uk/), extracting the information applicable to individual situations can be challenging and time consuming.
We have developed ‘FEC Check’ to simplify the understanding of faecal egg count results and assist with decision-making by visually demonstrating what the results mean clinically. The tool combats variation in reporting amongst providers, ensuring that everyone has access to the information they need to make knowledgeable management decisions.

Users input faecal egg count results and the app visualises the results on a graph with a colour gradient which represents the clinical impact i.e. green indicates low-level infection,
not requiring treatment, and red indicates that treatment is likely needed. The gradient is based on advice from the industry group Sustainable Control Of Parasites in Sheep (SCOPS). Links to reliable resources about sustainable roundworm control and testing have also been included in the app, including “how to collect good quality faecal samples” and “different uses of faecal egg counts”.
FEC Check uses
Monitoring: Regular faecal egg counting can be used to target treatments to optimal timepoints or individual animals requiring treatment. To aid decision making, the ‘monitoring’ mode provides a traffic light visual of the results indicating whether treatment should be considered.

Test whether treatment was effective: It’s important to know that treatments are working to ensure high animal health and avoid wasting limited time/resources.
The ‘efficacy testing’ mode visualises the reduction in roundworm eggs after treatment, comparing pre- and post-treatment results to provide the percentage reduction and information on what this means. Treatment failure can be due to administration/testing issues rather than anthelmintic resistance so a reliability checklist has been incorporated into the app – when all conditions have been met then you can be confident in the result shown.
The ‘post-treatment drench check’ mode can be used where a post-treatment test has been conducted but no pre-treatment test.
This will allow you to visualise the results and what they mean clinically but will not describe how well the treatment worked. This can be a useful indication though of whether parasite eggs are remaining after treatment in large numbers.
Testing can highlight the early stages of anthelmintic resistance, at which point actions can be taken to slow down its development. Examples include reducing the use of wormers by implementing targeted treatments, grazing management and ensuring every dose is given accurately. Where resistance is detected, faecal egg counts can be used to identify at which times of year those products can still be useful. Within the app there is a decision support tool, designed by SCOPS, for those with multiple anthelmintic resistance on their farm which provides tailored management suggestions to work through with your vet or animal health advisor.
Reliability checklist:
• Good quality faecal samples tested
• Pre-treatment FEC totals over 200 eggs per gram
• Correct dosing technique
Post-treatment samples collected only from treated sheep
• No other treatments given between sampling points e.g. Dectomax injection for sheep scab or a long-acting wormer (Moxidectin) less than 5 weeks prior to first sampling
• Different grazing groups of sheep did not mix between sampling points.
Moredun Magazine | Spring/Summer 2023 13 RESEARCH
FEC Check converts a typical results table of numbers into a visual graphic for ease of interpretation.

www.moredun.org.uk 3,500/JTCP
The Moredun Foundation is a company limited by guarantee, registered in Scotland No. SC151865. The Moredun Foundation is a charity registered in Scotland, No. SC022515. Address: Pentlands Science Park, Bush Loan, Penicuik, Midlothian, Scotland, EH26 0PZ.